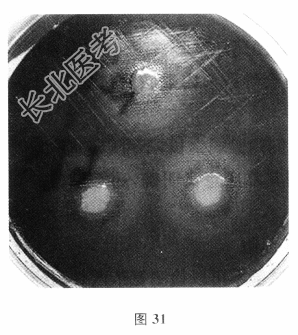
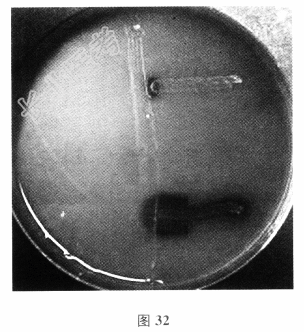

试题详情
- [材料题] 男性,23岁。因发热、头痛逐渐加重1周,喷射性呕吐2天入院。体检:T38℃,R20次/分,P86次/分,BP15/10kPa。颈部见淡红丘疹,双瞳孔等圆等大,对光反射灵敏。颈抵抗,颏胸距3横指,克氏征(+)。呼吸音清,无啰音,心律齐,无杂音;腹软,无压痛,肝脾不大;双下肢无水肿,膝腱反射正常,巴氏征(-)。实验室检查:血白细胞11.03×109/L,中性粒细胞75%,淋巴细胞21%,血沉11mm/h,生化无异常(略)。脑脊液(CSF)检查:淡黄色,清亮,蛋白(++),红细胞38×106/L,白细胞317×106/L,隐球菌抗原(-),抗酸杆菌染色(-),氯化物123.5mmol/L,糖0.1mmol/L,蛋白1.44g/L。
- 多项选择题1.该患者高度疑似细菌性脑膜炎,抽取脑脊液进行涂片检查,有何要求()
A、脑脊液革兰染色涂片检查属于急查项目,收到标本后30分钟内回报结果
B、脑脊液革兰染色涂片检查不属于急查项目
C、脑脊液墨汁染色检查没有临床意义,建议废止
D、脑脊液新型隐球菌荚膜多糖试验快速、敏感,如果有该检查,则墨汁染色可以废止
E、脑脊液不能进行抗酸染色检查
F、尽管抗酸染色检查敏感性低,但不能除外结核时,可以进行该项检查
关注下方微信公众号,搜题查看答案

- 多项选择题2.脑脊液细菌培养标准培养基配置包括巧克力培养基,为了分离哪一个菌种()
A、大肠埃希菌
B、流感嗜血杆菌
C、肺炎链球菌
D、铜绿假单胞菌
E、结核分枝杆菌
F、脑脊液培养不需要巧克力培养基
关注下方微信公众号,搜题查看答案

- 多项选择题3.图28~图33属于卫星现象的是()
A、

B、

C、

D、
E、
F、

关注下方微信公众号,搜题查看答案

- 多项选择题4.关于流感嗜血杆菌药敏试验,有哪些注意事项()
A、菌悬液浓度高时会导致β内酰胺酶试验假阳性,所以0.5McF需要很准确
B、复方磺胺的抑菌圈内微弱生长,不可以忽略
C、脑脊液分离株因其临床意义明确,药敏试验需要尽可能多地纳入测试药物
D、需要用加血MH琼脂
E、直接β内酰胺酶试验不可以检测氨苄西林耐药性
F、β内酰胺酶阴性而氨苄西林耐药(BLNAR)的菌株多见
关注下方微信公众号,搜题查看答案

热门试题
- 下列哪项试验不是细菌的生化反应A、靛基质
- 组织培养是分离和培养病毒以及进行病毒学实
- 暗视野显微镜要求载玻片和盖玻片需清洁无划
- 1、社区获得性肺炎常见病原菌包括哪些()
- 1、您作为检验人员,建议临床医生行胸腔积
- 1、考虑血流感染,血培养标本采集的正确方
- 葡萄球菌食物中毒,动物接种的鉴别诊断中所
- 从环境样品中分离细菌的最好方法是A、平板
- 细胞培养液中加入下列哪种成分可使培养液具
- 1、您作为临床微生物实验室人员,首先制备
- 1、下列哪些情况应怀疑厌氧菌感染()A、
- 关于DMSO错误的描述是A、保存病毒标本
- 凝胶过滤法主要用于蛋白和核酸分离,又称为
- 不属于ELISA的方法是A、间接法B、中
- 1、您作为临床检验人员,建议临床医生行脑
- 1、涂片示革兰阳性杆菌,两端平齐,呈竹节
- 暗视野显微镜常用于以下哪种标本的检查A、
- 鉴定厌氧菌用下述哪种鉴定试卡A、GPIB
- 1、关于血培养下列哪项是正确的()A、通
- 细胞培养中使用的Versen又称为A、E